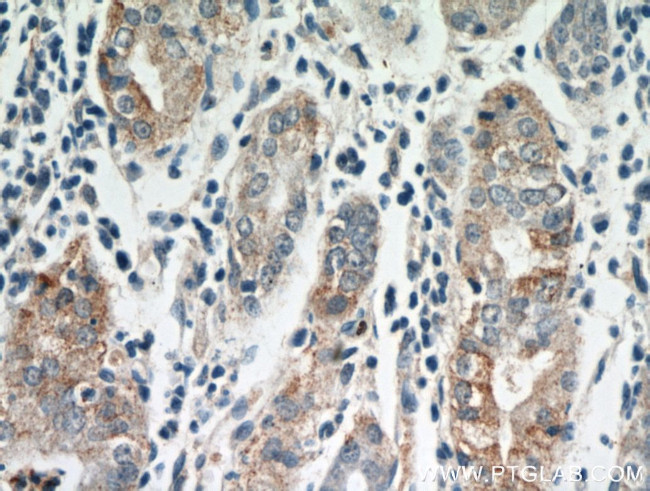
MOGAT2 Antibody in Immunohistochemistry (Paraffin) (IHC (P))

Search
Proteintech
MOGAT2 Polyclonal Antibody
{{$productOrderCtrl.translations['antibody.pdp.commerceCard.promotion.promotions']}}
{{$productOrderCtrl.translations['antibody.pdp.commerceCard.promotion.viewpromo']}}
{{$productOrderCtrl.translations['antibody.pdp.commerceCard.promotion.promocode']}}: {{promo.promoCode}} {{promo.promoTitle}} {{promo.promoDescription}}. {{$productOrderCtrl.translations['antibody.pdp.commerceCard.promotion.learnmore']}}
产品信息
21286-1-AP
种属反应
宿主/亚型
分类
类型
抗原
偶联物
形式
浓度
规格
纯化类型
保存液
内含物
保存条件
运输条件
产品详细信息
Immunogen sequence: LLTVLYAAW WYLDRDKPRQ GGRHIQAIRC WTIWKYMKDY FPISLVKTAE LDPSRNYIAG FHPHGVLAVG AFANLCTEST GFSSIFPGIR PHLMMLTLWF RAPFFRDYIM SAGLVTSEKE SAAHILNRKG GGNLLGIIVG GAQEALDARP GSFTLLLRNR KGFVRLALTH G (48-217 aa encoded by BC103878)
靶标信息
Dietary fat absorption from the small intestine is facilitated by acyl-CoA:monoacylglycerol transferase (MOGAT; EC 2.3.1.22) and acyl-CoA:diacylglycerol acyltransferase (DGAT; see MIM 604900) activities. MOGAT catalyzes the joining of monoacylglycerol and fatty acyl-CoAs to form diacylglycerol (Yen and Farese, 2003 ).
仅用于科研。不用于诊断过程。未经明确授权不得转售。
篇参考文献 (0)
生物信息学
蛋白别名: 2-acylglycerol O-acyltransferase 2; acyl CoA:monoacylglycerol acyltransferase 2; Acyl-CoA:monoacylglycerol acyltransferase 2; Diacylglycerol acyltransferase 2-like protein 5; Diacylglycerol O-acyltransferase candidate 5; FLJ22644; hDC5; hMGAT2; MGAT2; MGC119183; MGC119184; MGC119185; Monoacylglycerol O-acyltransferase 1-like; Monoacylglycerol O-acyltransferase 2; unnamed protein product
基因别名: DC5; DGAT2L5; DGAT2L5.; hDC5; Mgat1l; MGAT2; MOGAT2
UniProt ID: (Human) Q3SYC2, (Mouse) Q80W94
Entrez Gene ID: (Human) 80168, (Mouse) 233549, (Rat) 681211